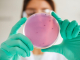
infezioni leucemia linfoblastica acuta

Cure palliative pediatriche e qualità della vita: i bisogni dei bambini oncologici in Italia
Mettere al centro il bambino, e non solo la malattia. È questo l’obiettivo dello studio sui bisogni insoddisfatti nei pazienti oncologici pediatrici eleggibili alle cure palliative, che offre una fotografia inedita della realtà italiana, esplorando quanto...